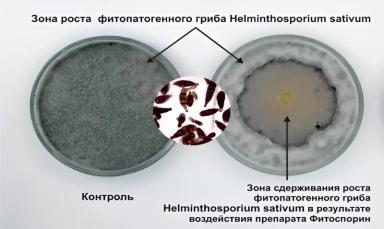
Использование комплексов микроорганизмов для защиты от фитопатогенов
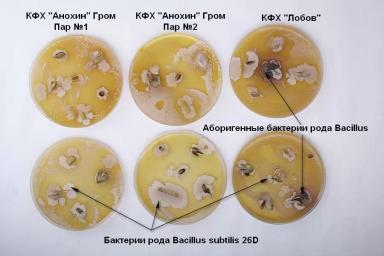
ФИТОСПОРИН АС, Ж – НОВЫЙ УРОВЕНЬ БИОЗАЩИТЫ!

ООО "НВП "БАШИНКОМ"
Во время осеннего кущения озимая пшеница проходит процессы закаливания, повышающие ее зимостойкость. В этих процессах, важную роль играют сахара, которое накапливает растение. При перезимовке ...
Современная предпосевная обработка семенного материала – это комплексное мероприятие, поскольку на семенной материал, кроме фунгицидных или инсекто-фунгицидных протравителей, наносят защитно-стимулирующие препараты, содержащие стимуляторы роста растений, комплексные удобрения, содержащие макро-, ...
В Башкортостане работает уникальное производство, которое по праву называют одним из лидеров биотехнологической отрасли России. Здесь выпускают около ...
Сегодня чрезвычайно актуальна задача разработки и применения эффективных биологических фунгицидов для борьбы с возбудителями болезней.
Биологические фунгициды создаются на основе различных родов и видов почвенных микроорганизмов, обладающих выраженным ...
Микориза – это процесс, при котором грибы устанавливают взаимовыгодное партнерство с корнями растений. Микориза является важным симбиотическим взаимодействием между растениями и грибами. Микоризные грибы образуют арбускулы – специализированные гифы, ...
Азот – жизненно необходимый макроэлемент питания растений. Без его участия невозможно развитие растений. Он отвечает за обмен веществ и является строительным элементом ...
Однокомпонентные препараты, решающие только одну задачу в агрономии, постепенно сдают свои позиции. Сегодня, земледельцы заинтересованы в применении комбинированных многокомпонентных препаратов, положительно влияющих на рост и развитие растений.
Современные ...

